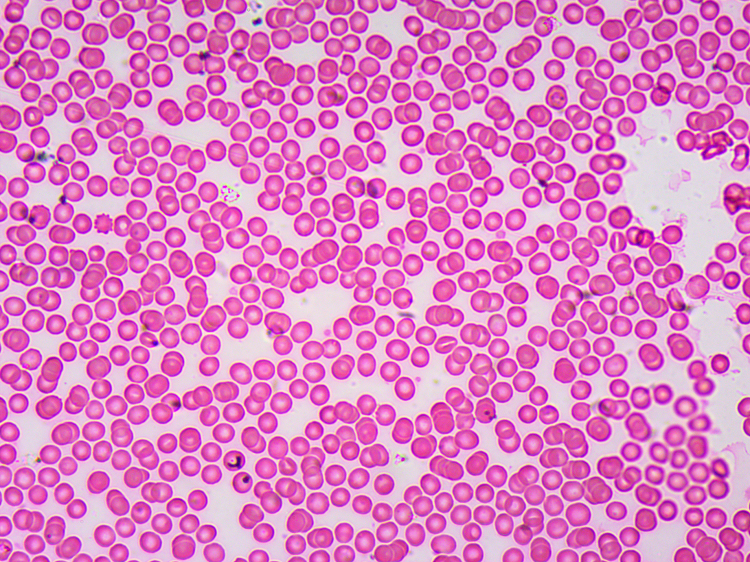
生物显微镜常规标本切片套装动物植物组织细胞玻璃载玻片学生实验

人血涂片显微镜图片

人血教学玻片
图片尺寸1000x2000
放张血涂片镇楼,此人单纯疱疹就诊的
图片尺寸720x533
外周血片
图片尺寸2000x2000
显微镜下的人血涂片,白细胞在视野中央
图片尺寸960x1280
外周血涂片.#显微镜下的世界 ,#血细胞形态观察 ,#检验科 - 抖音
图片尺寸1440x1920
学涂片请教下面血涂片有原始细胞吗
图片尺寸3264x1840
外周血涂片
图片尺寸1600x1200
一目了然:显微镜下的别样天地
图片尺寸640x480
人血涂片红细胞白细胞显像清晰易观察生物显微镜标本切片显微玻片
图片尺寸1000x1000
学涂片请教下面血涂片有原始细胞吗
图片尺寸3264x1840血涂片.
图片尺寸1100x1108
生物显微镜常规标本切片套装动物植物组织细胞玻璃载玻片学生实验
图片尺寸750x562
学涂片请教下面血涂片有原始细胞吗
图片尺寸3264x1840
白血病血涂片 2年前
图片尺寸1440x1920
维克科教郑州血涂片厂家教学器具专业研发生产厂家
图片尺寸600x600
红细胞 白细胞 人血的永久涂片
图片尺寸1080x810
人血涂片(400×)①红细胞 ②嗜酸性粒细胞 ③嗜中性粒细胞 ④单核细胞
图片尺寸455x289血涂片
图片尺寸1100x1107
学涂片请教下面血涂片有原始细胞吗
图片尺寸3264x1840
学涂片请教下面血涂片有原始细胞吗
图片尺寸3264x1840
猜你喜欢:显微镜人血涂片手绘图人血细胞示意图血涂片显微镜下图片标准血涂片神经元显微镜图片细菌图片显微镜下血涂片细胞形态图片人血涂片显微镜人血涂片示意图人血细胞显微镜图人血显微镜下细胞画图口腔上皮细胞图片人血细胞结构图手绘图人血涂片结构示意图人血细胞人血涂片结构图鸡血涂片显微镜图片人血涂片显微镜结构图显微镜观察人血涂片人血涂片的细胞图片血涂片血小板图片人血永久涂片图片显微镜下血涂片的绘图血涂片图片细菌图片显微镜血涂片各种细胞的图片显微镜图片结构图正常血涂片报告单图片疟原虫图片血涂片人血涂片绘图吉隆坡塔和双子塔天若有情2电视剧樱花树飘落飞影壁纸将军柱仙人掌在床上拍床的表情包赌侠电影qq飞车赛车图片 原画鸡菌图片王成毅医生动漫可爱动物二次元吉他fdim7和弦